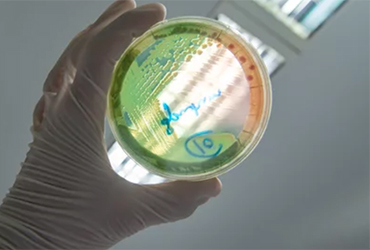

The antibiotics ceftazidime-avibactam (Avycaz, AbbVie) and ceftolozane-tazobactam (Zerbaxa, Merck) remain very active against Pseudomonas aeruginosa, with overall susceptibility rates of 97.0% and 97.6%, respectively, according to results of a new study presented at IDWeek 2025, in Atlanta (abstract P1313).
However, susceptibility to these agents decreased slightly from 2015 to 2024.
The INFORM Program
Investigators with Element/JMI Laboratories evaluated the antimicrobial susceptibility of P. aeruginosa isolates from U.S. medical centers in the last 10 years, using data from the International Network for Optimal Resistance Monitoring (INFORM) program, which monitors the in vitro activity of ceftazidime-avibactam and other antimicrobial agents against P. aeruginosa and Enterobacteriaceae isolates worldwide.
In the United States, bacterial isolates are collected according to infection types and sent to JMI Laboratories in North Liberty, Iowa, where they are tested for susceptibility by reference broth microdilution methods against most antimicrobial agents used to treat systemic gram-negative infections.
Measuring Susceptibility
A total 14,305 P. aeruginosa isolates (one per patient) were consecutively collected from 56 U.S. medical centers in 2015-2024 and susceptibility tested against 17 antimicrobials by reference broth microdilution. Investigators only included centers that contributed to isolates for at least eight years. They stratified susceptibility results by year and infection type. Multidrug resistance was defined as resistance to at least three classes. Extensively drug-resistant was defined as susceptibility to two or fewer classes, and difficult-to-treat was defined as nonsusceptible to piperacillin-tazobactam, cephalosporins, carbapenems, fluoroquinolones, and aminoglycosides.
The investigators found that most active compounds were ceftazidime-avibactam and ceftolozane-tazobactam. Nonsusceptibility rates for these agents increased from 1.8% and 1.4%, respectively, in 2015 to 3.2% and 2.5% in 2024. Nonsusceptibility rates increased for piperacillin-tazobactam from 17% in 2015 to 22.5% in 2024, with marked variation during the period. Nonsusceptibility rates for meropenem, levofloxacin, and tobramycin increased from 2015 to 2017, then decreased from 2017 to 2022-2023, and then increased again in 2024.
Ceftazidime-avibactam was active against 83% of multidrug-resistant, 66% of extensively drug-resistant, and 65.3% of difficult-to-treat isolates. Ceftolozane-tazobactam was active against 85.9% of multidrug-resistant, 64.3% of extensively drug-resistant, and 71.9% of difficult-to-treat isolates. Susceptibility rates were lower among isolates from pneumonia compared with other infections.
The study authors reported several financial relationships with antibiotics producers, including to AbbVie, the maker of Avycaz.